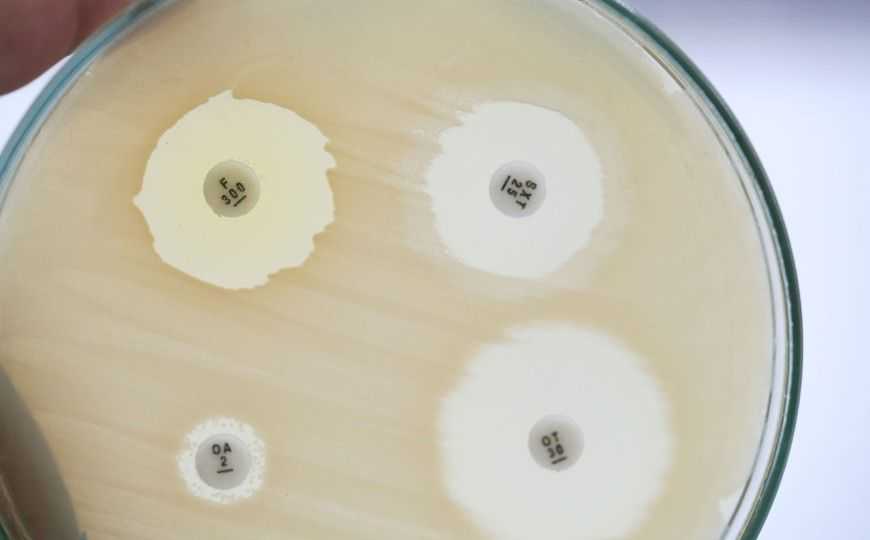

Врачей призвали воздержаться от необоснованного назначения антибиотиков при COVID-19
Российская Межрегиональная ассоциация по клинической микробиологии и антимикробной химиотерапии (МАКМАХ) напомнила, что бездумное применение антибиотиков при COVID-19 способствует росту антимикробной резистентности.
Межрегиональная ассоциация по клинической микробиологии и антимикробной химиотерапии опубликовала письмо за подписью члена-корреспондента РАН Романа Козлова, главного внештатного специалиста Минздрава РФ по клинической микробиологии и антимикробной резистентности, президента МАКМАХ.
«На фоне пандемии новой коронавирусной инфекции в России отмечен значительный рост продажи антибактериальных препаратов в аптеках и закупок их лечебными учреждениями, — говорится в письме. — По данным ряда исследований, более 90% пациентов с COVID-19 в настоящее время получают антибиотики, в том числе комбинированную терапию и парентеральные препараты не только в стационарах, но и в амбулаторных условиях. Вне всякого сомнения, сложившая ситуация будет способствовать значительному росту антимикробной резистентности и иметь серьёзные неблагоприятные последствия в будущем».
МАКМАХ дает следующие разъяснения.
«1. Антибактериальные препараты не активны в отношении вирусов, в том числе в отношении возбудителя COVID-19 — нового коронавируса SARS-Cov-2. Поэтому COVID-19, как и любая другая вирусная инфекция, не является показанием для применения антибиотиков.
2. Назначение антибактериальной терапии у пациентов с COVID-19 оправдано только при наличии убедительных признаков бактериальной инфекции, включая лейкоцитоз, появление гнойной мокроты и повышение уровня прокальцитонина ≥0,5 нг/мл.
3. Особенно частым ошибочным назначением антибиотика является назначение азитромицина и других макролидов в амбулаторных условиях пациентам с подтвержденным или предполагаемым диагнозом нетяжелых форм COVID-19 без признаков бактериальной инфекции в расчете на их иммуномодулирующее действие.
4. Действительно, в рекомендациях МЗ РФ по профилактике, диагностике и лечению коронавирусной инфекции рассматривается возможность использования комбинации гидроксихлорохин + азитромицин. Однако эти рекомендации основаны на ранних публикациях немногочисленных клинических наблюдений. Позднее проведенные исследования не только не показали эффективность такой терапии при COVID-19, но и продемонстрировали опасность данной комбинации для жизни пациентов ввиду неблагоприятных лекарственных реакций со стороны сердечно-сосудистой системы.
5. У пациентов с COVID-19 использование макролидов оправдано только при обоснованном подозрении на развитие тяжёлой внебольничной бактериальной пневмонии на фоне вирусной инфекции, при этом макролиды применяются в комбинации с антипневмококковыми β‑лактамными антибиотиками. То же самое касается и использования респираторных фторхинолонов.
6. При развитии нозокомиальной (внутрибольничной) бактериальной пневмонии у пациентов с COVID-19 антибактериальная терапия проводится по общим правилам — с учетом тяжести состояния пациента, локальной эпидемиологии антибиотикорезистентности в стационаре/отделении, факторов риска инфекции, вызванной резистентными бактериями, результатов микробиологической диагностики.
Учитывая вышесказанное, призываем практических врачей и руководителей медицинских организаций, оказывающих помощь пациентам с новой коронавирусной инфекцией COVID-19, отказаться от необоснованного назначения антибиотиков и в амбулаторных условиях, и в условиях стационара».
Член-корреспондент РАН Роман Козлов (и.о. ректора Смоленского государственного медицинского университета, директор НИИ антимикробной химиотерапии СмолГМУ) постоянно напоминает о том, что проблема антибиотикорезистентности должна обсуждаться на государственном уровне. В своем докладе на пленарном заседании конференции «Молекулярная диагностика 2018» в Минске он приводил оценки, говорящие о том, что антимикробная устойчивость уже к середине века может привести к десяткам миллионов смертей в год, фактически к возвращению в эпоху до антибиотиков. Поэтому крайне важна оптимизация использования давно применяемых в клинике препаратов, их нельзя назначать бездумно: «Помните, беря в руки антибиотик, что это невосстановимый ресурс человечества».
Источник
О применении антибактериальных препаратов у пациентов с новой коронавирусной инфекцией COVID-19 // ANTIBIOTIC.ru // 27 октября 2020


 Меню
Меню





 Все темы
Все темы




 0
0











